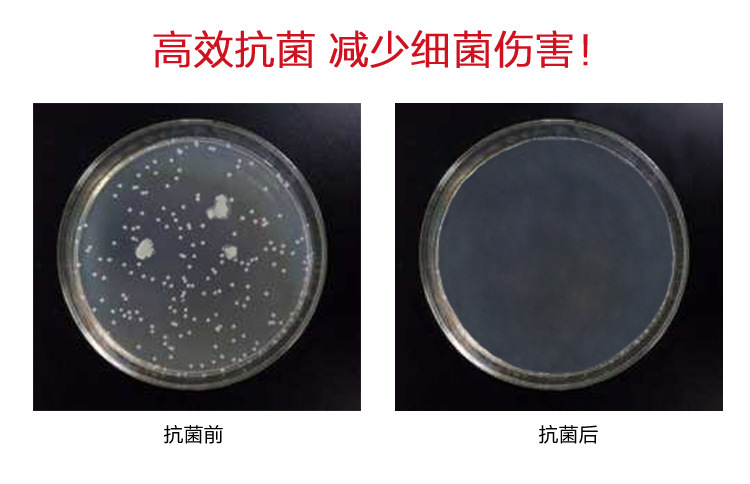
GA7

联系人:刘先生
邮箱:rixinm@163.com
电话:18028970491
地址: 广东东莞市常平镇陈屋贝旧围街10号101室

纳米抗菌剂GA7
GA7纳米抗菌剂是银系抗菌剂,以磷酸锆为载体,把具有抗菌作用的银离子以稳定的形态均匀分布到载体中,具有强抗菌作用,高安全性,强耐热性,化学稳定性好,不产生耐药性等,可灭杀650多中细菌和病毒,特别是克雷伯氏菌,大肠杆菌,金黄色葡萄球菌,白色念珠菌等各类致病菌进行高效广谱的抑制与杀灭,与其他抗菌剂比具有耐高温,效果持久等特性,是一种理想的抗菌产品添加剂,广泛用于塑胶,硅胶,涂料,陶瓷等非金属材料的抗菌改性,物理化学性能十分稳定,具有良好的抗变色性能和持久的抗菌性能,适用于注塑,挤出,吹膜,抽丝,流延等工艺。
产品特点
1.卓越的抗菌性能,广谱的杀菌性能,对大肠杆菌,黄色葡萄球菌,克雷伯氏菌,绿脓杆菌,白色念球菌,黑曲霉等均有很好的效果,也可以长期抑制这些细菌在材料表面的繁殖并不产生耐药性能,对典型微生物的抑制发育浓度(MIC)mg/kg:
大肠杆菌120PPM
金黄色葡萄球菌120PPM
白色念珠菌120PPM
2.理化性质稳定,耐高温,长效抗菌,可以长时间维持塑胶材料的卫生性能
3.粒度小,不变色,可用于薄膜,医疗器械,塑料等
4.高的安全性:满足食品接触材料添加要求
产品指标
外观:白色粉末
颗粒度:小于1微米
水份:小于1.0%
耐温性:大于1000度
白度:大于95
银含量:大于3%
PH(1%水溶液):6-8
使用范围:橡塑,陶瓷,涂料,塑料,日化

使用说明
塑料应用中,可预先制成抗菌母粒,再按照一定比例加入塑料中,建议用量为0.5-1.0%
在橡胶制品上可在加工过程直接加入,建议用量为0.5-1.0%
在陶瓷制品上,建议用量为6-10%
在涂料中,建议用量为0.1-1%
在硅胶制品中,先分散于比较稀的组分,分散均匀,建议用量3-5%,注意如果交联剂中含硫成分,富含强氧化剂,制品有可能变黄。







包装和存储
保质量期:2年
储存方式:干燥阴凉通风处,产品开启后请尽快用







